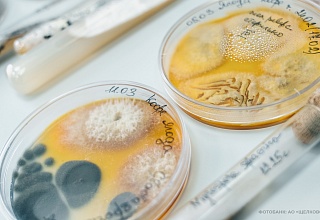

- О компании
Направления деятельностиСредства защиты растений Специальные удобрения Семена Центр селекции и семеноводства «Бетагран Семена» Селекционно-генетический центр ООО «СоюзСемСвекла» Производство семян в ООО «Бетагран Рамонь» Опытное хозяйство ООО «Дубовицкое» Производство сетки для защиты садов ООО «Бетанет» ООО «Бетагран Кубань» Производство эмбрионов и семени КРС ООО «Бетагран Липецк» Продукция для дачников Продукция для фермеров
- Продукция
- Культуры
- Агросправочник
- Медиа
- Новости
- Контакты